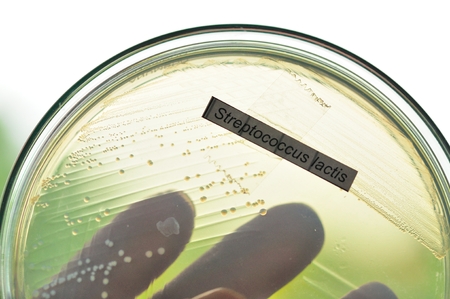
streptococcus lactis in petridishの写真素材

写真素材 - streptococcus lactis in petridish
キーワード
- agar
- antibiotic
- bacteria
- bacterial
- biology
- biotechnology
- blue
- chemical
- colony
- culture
- drug
- education
- experiment
- experimental
- fungi
- grow
- growth
- healthcare
- investigation
- lab
- laboratory
- macro
- medical
- medicine
- microbiology
- microorganisms
- molecular
- organism
- penicillin
- penicillum
- petri
- plate
- research
- science
- strain
- streptococcus
- streptococcus lactis
- study
- dish
類似作品
detail of bacte...
bacteria colony...
Different bacte...
Magnified view ...
Backgrounds of ...
This image show...
Microscopic vie...
Backgrounds of ...
Macro close up ...
Microscopic vie...
Detailed image ...
texture of a st...
Backgrounds of ...
lymphocyte, Pha...
Bacillus sp. on...
a close up imag...
Bacterial colon...
Science and Lif...
Jar filled with...
a close up imag...
Backgrounds of ...
bacteria colony...
close-up of sci...
Close-up of vir...
Science and Lif...
Petri dish grow...
Petri dish with...
macro of bacter...
Abstract concep...
a glass ball on...
development, re...
Colonies of oil...
Mold
Abstract concep...
A close-up of a...
Abstract concep...
Isolated bacter...
bacteria colony...
Top view soil m...
Bacteria and vi...
A petri dish wi...
Characteristics...
Colorful fluid ...
Close up of bac...
microbial cultu...
Scientist hands...
ass of the pan ...
Penicillium, as...
Petri Dish with...